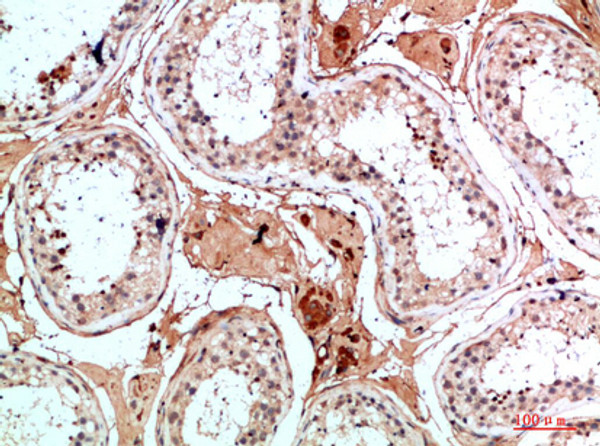
Immunohistochemical analysis of paraffin-embedded human-testis, antibody was diluted at 1:200

Anti-NANOS1 antibody (151-200 aa) (STJ98619)
SPECIFICATIONS
ClonalityPolyclonal
HostRabbit
ConjugationUnconjugated
IsotypeIgG
ImmunogenSynthesized peptide derived from Nanos Homologue 1 (NANOS1) at the amino acid range 151-200
General Information
| Short Description | Rabbit polyclonal anti-Nanos homolog 1 (151-200 aa) for use in WB, ELISA and IHC in Human, Rat and Mouse samples. Datasheet included with dilution recommendations, and related reagents. |
| Applications | WB/ELISA/IHC |
| Host | Rabbit |
| Reactivity | Human/Rat/Mouse |
| Note | STRICTLY FOR FURTHER SCIENTIFIC RESEARCH USE ONLY (RUO). MUST NOT TO BE USED IN DIAGNOSTIC OR THERAPEUTIC APPLICATIONS. |
Product Properties
| Clonality | Polyclonal |
| Isotype | IgG |
| Conjugation | Unconjugated |
| Concentration | 1 mg/mL |
| Purification | The antibody was affinity-purified from rabbit antiserum by affinity-chromatography using epitope-specific immunogen. |
| Dilution Range | WB 1:500-2000IHC-P 1:50-300ELISA 2000-20000 |
| Formulation | Liquid in PBS containing 50% Glycerol, 0.5% BSA and 0.02% Sodium Azide. |
| Storage Instruction | Store at-20°C for up to 1 year from the date of receipt, and avoid repeat freeze-thaw cycles. |
Target Information
| Gene Symbol | NANOS1 |
| Gene ID | 340719 |
| Uniprot ID | NANO1_HUMAN |
| Immunogen | Synthesized peptide derived from Nanos Homologue 1 (NANOS1) at the amino acid range 151-200 |
| Immunogen Region | 151-200 aa |
| Specificity | Nanos Homologue 1 (NANOS1) Polyclonal Antibody detects endogenous levels of Nanos Homologue 1 (NANOS1) |
Additional Info
| Function | May act as a translational repressor which regulates translation of specific mRNAs by forming a complex with PUM2 that associates with the 3'-UTR of mRNA targets. Capable of interfering with the proadhesive and anti-invasive functions of E-cadherin. Up-regulates the production of MMP14 to promote tumor cell invasion. |
| Protein Name | Nanos Homolog 1Nos-1Ec_rep1a |
| Database Links | |
| Cellular Localisation | CytoplasmPerinuclear RegionColocalizes With Snapin And Pum2 In The Perinuclear Region Of Germ Cells |
| Alternative Antibody Names | Anti-Nanos Homolog 1 antibodyAnti-Nos-1 antibodyAnti-Ec_rep1a antibodyAnti-NANOS1 antibodyAnti-NOS1 antibody |
Information sourced from Uniprot.org